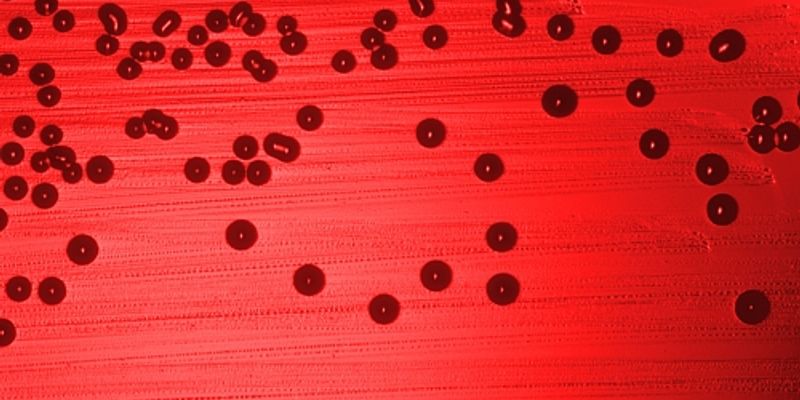

Conjugate Vaccine
Conjugate Vaccine: combine a weak antigen with a strong antigen so that the immune system has a stronger response to the weak antigen. Vaccines are used to prevent diseases by invoking an immune response to an antigen, the foreign part of a bacteria or virus that the immune system recognizes.
What's Popular in Conjugate Vaccine
-
JUN 29, 2023NeuroscienceGlioblastoma is a type of rare brain cancer that originates in the brain or spinal cord. Glioblastoma can occur at ...Written By: Greta AnneFEB 17, 2022ImmunologyA workout after getting a vaccine for influenza or COVID-19 may provide additional immune protection, says a new ...Written By: Tara FernandesDEC 09, 2021ImmunologyAdjuvants are molecules added to vaccines to help them work better by stimulating a stronger immune response. This appro ...Written By: Tara FernandesNOV 30, 2021ImmunologyHIV is a master of disguise. Once the virus enters the body, it has a number of sophisticated mechanisms through which i ...Written By: Tara FernandesJUN 24, 2021ImmunologyIn a study reported in the journal Cell, immunologists provide evidence for an Achilles’ heel in current COVI ...Written By: Tara Fernandes
JUN 29, 2023
Neuroscience
Glioblastoma is a type of rare brain cancer that originates in the brain or spinal cord. Glioblastoma can occur at
...
Written By:
Greta Anne
FEB 17, 2022
Immunology
A workout after getting a vaccine for influenza or COVID-19 may provide additional immune protection, says a new
...
Written By:
Tara Fernandes
DEC 09, 2021
Immunology
Adjuvants are molecules added to vaccines to help them work better by stimulating a stronger immune response. This appro
...
Written By:
Tara Fernandes
NOV 30, 2021
Immunology
HIV is a master of disguise. Once the virus enters the body, it has a number of sophisticated mechanisms through which i
...
Written By:
Tara Fernandes
JUN 24, 2021
Immunology
In a study reported in the journal Cell, immunologists provide evidence for an Achilles’ heel in current COVI
...
Written By:
Tara Fernandes
JUN 01, 2021
Immunology
Seasonal flu vaccines only work around 40 to 60 percent of the time, says the U.S. Centers for Disease Control and Preve
...
Written By:
Tara Fernandes
MAY 24, 2021
Cell & Molecular Biology
Asthma is thought to affect 340 million people. A type of asthma that happens when allergens like dust mites are inhaled
...
Written By:
Carmen Leitch
APR 27, 2021
Immunology
University of Oxford scientists have developed a vaccine against malaria, which they describe as having “unprecede
...
Written By:
Tara Fernandes
APR 15, 2021
Immunology
Good news for families of newborns: A new study shows that breastfeeding mothers who receive a COVID vaccine share prote
...
Written By:
Tara Fernandes
-
DEC 08, 2021 | 8:00 AMDate: December 08, 2021 Time: 8:00am (PDT), 11:00am (EDT) Learn how enrichment of primary dendritic cell (DC) subsets and sustainable DC manufacturing advances DC-based cell therapies. In th...OCT 07, 2021 | 8:00 AMDate: October 7, 2021 Time: 8:00am (PDT), 11:00am (EDT) To combat the COVID-19 pandemic, comprehensive characterization of humoral and cellular immune responses to SARS-CoV-2 is essential. A...Platform based therapeutics and vaccines offer a unique opportunity to simplify and streamline the drug development process. Moderna has taken the approach of harnessing the power of mRNA as...Speaker: Joseph J. Senn, PhD, DABTPresented at: Drug Discovery & Development Virtual Event Series 2021
SEP 10, 2020 | 9:00 AM
Date: September 10, 2020 Time: 9:00am (PDT), 12:00pm (EDT) Osmolality testing is relevant throughout the entire bioprocessing workflow. As customers look to refine mAb and gene therapy workf...
AUG 06, 2020 | 10:00 AM
DATE: August 6th, 2020 TIME: 10:00am PT In recent years Lilly has implemented a Next Generation Research (NGR) initiative to improve the value output of the R&D portfolio. One of the NGR...
DEC 08, 2021 | 8:00 AM
Date: December 08, 2021 Time: 8:00am (PDT), 11:00am (EDT) Learn how enrichment of primary dendritic cell (DC) subsets and sustainable DC manufacturing advances DC-based cell therapies. In th...
OCT 07, 2021 | 8:00 AM
Date: October 7, 2021 Time: 8:00am (PDT), 11:00am (EDT) To combat the COVID-19 pandemic, comprehensive characterization of humoral and cellular immune responses to SARS-CoV-2 is essential. A...
Platform based therapeutics and vaccines offer a unique opportunity to simplify and streamline the drug development process. Moderna has taken the approach of harnessing the power of mRNA as...
Speaker:
Joseph J. Senn, PhD, DABT
Presented at: Drug Discovery & Development Virtual Event Series 2021
SEP 10, 2020 | 9:00 AM
Date: September 10, 2020 Time: 9:00am (PDT), 12:00pm (EDT) Osmolality testing is relevant throughout the entire bioprocessing workflow. As customers look to refine mAb and gene therapy workf...
AUG 06, 2020 | 10:00 AM
DATE: August 6th, 2020 TIME: 10:00am PT In recent years Lilly has implemented a Next Generation Research (NGR) initiative to improve the value output of the R&D portfolio. One of the NGR...
Purpose: Group B Streptococcus (GBS) is a Gram positive coccus which is part of the normal microbiota of the GI and GU tracts. However GBS is also a major cause of septicaemia and meningitis...
The recent Zika virus outbreak highlights the need for low-cost diagnostics that can be rapidly developed for distribution and use in pandemic regions. In early 2016 we developed a pipe...
Speaker:
Keith Pardee, PhD
-
SEP 08, 2021 | 6:00 AM PDTLuminex's xMAP® Technology enables the evaluation of up to 500 analytes simultaneously in a single well, known as multiplexing. xMAP Technology uses color-coded microspheres as the substrate...JUL 22, 2021 | 5:00 AM PDTGene and cell engineering advances have influenced almost all branches of life sciences. From the lab to the clinic, innovative gene synthesis technologies and gene editing tools have transf...Each step in a diagnostic test's journey-from raw material extraction to patient administration-can influence outcomes....MAR 16, 2021 | 5:00 AM PDTJoin the two-Day Virtual IVD Conference on advancing immunoassay tech and performance Making an in vitro diagnostic assay has never been easy. Now with the global lab and supply chain and di...SEP 01, 2020 | 10:30 AMThis 2-day virtual event organized across the Asia Pacific region aims to serve as a platform to share scientific knowledge and provide a discourse on the topic of infectious disease and imm...
SEP 08, 2021
| 6:00 AM PDT
Luminex's xMAP® Technology enables the evaluation of up to 500 analytes simultaneously in a single well, known as multiplexing. xMAP Technology uses color-coded microspheres as the substrate...
JUL 22, 2021
| 5:00 AM PDT
Gene and cell engineering advances have influenced almost all branches of life sciences. From the lab to the clinic, innovative gene synthesis technologies and gene editing tools have transf...
Each step in a diagnostic test's journey-from raw material extraction to patient administration-can influence outcomes....
MAR 16, 2021
| 5:00 AM PDT
Join the two-Day Virtual IVD Conference on advancing immunoassay tech and performance Making an in vitro diagnostic assay has never been easy. Now with the global lab and supply chain and di...
SEP 01, 2020
| 10:30 AM
This 2-day virtual event organized across the Asia Pacific region aims to serve as a platform to share scientific knowledge and provide a discourse on the topic of infectious disease and imm...
SEP 12, 2018
| 6:00 AM PDT
Join Labroots in bringing the microbiology research community together at the 3rd Annual Event in the Microbiology and Immunology Virtual Event Series! During the free...
OCT 11, 2017
| 6:00 AM PDT
The 5th Annual Event in the Cancer Research & Oncology Week Virtual Event Series is now On-Demand!...
MAY 09, 2017
| 7:00 PM PDT
Explore the world's largest protein expression virtual event on-demandThe Gibco™ ExpressionWorld™ virtual conference is the world’s largest online venue for experien...
NOV 02, 2016
| 6:00 AM PDT
The 7th Annual Event in the Clinical Diagnostics & Research Virtual Event Series! conference is now On Demand! This premiere venue discusses the latest advances in clinical diagnostics, ...